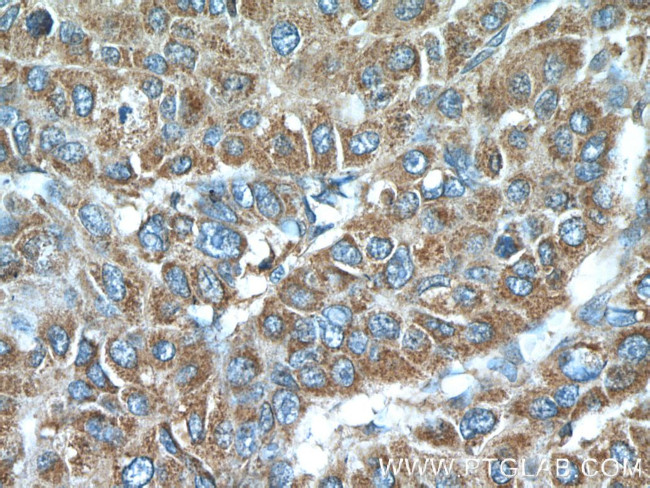
LY6E Antibody in Immunohistochemistry (Paraffin) (IHC (P))
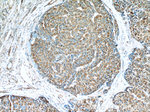
LY6E Antibody in Immunohistochemistry (Paraffin) (IHC (P))

Search
Proteintech
LY6E Polyclonal Antibody
{{$productOrderCtrl.translations['antibody.pdp.commerceCard.promotion.promotions']}}
{{$productOrderCtrl.translations['antibody.pdp.commerceCard.promotion.viewpromo']}}
{{$productOrderCtrl.translations['antibody.pdp.commerceCard.promotion.promocode']}}: {{promo.promoCode}} {{promo.promoTitle}} {{promo.promoDescription}}. {{$productOrderCtrl.translations['antibody.pdp.commerceCard.promotion.learnmore']}}
产品信息
22144-1-AP
种属反应
宿主/亚型
分类
类型
抗原
偶联物
形式
浓度
规格
纯化类型
保存液
内含物
保存条件
运输条件
产品详细信息
Immunogen sequence: LMCFSCLNQ KSNLYCLKPT ICSDQDNYCV TVSASAGIGN LVTFGHSLSK TCSPACPIPE GVNVGVASMG ISCCQSFLCN FS (21-101 aa encoded by BC119708)
靶标信息
Sca1, also known as Ly6A/E, is a member of the Ly6 multigene family of type V glycophosphatidylinositol anchored cell surface proteins. It is expressed on multipotent hematopoietic stem cells in bone marrow of mice with both the Ly6.1 and Ly6.2 allotypes. In the periphery, Sca1 exhibits a pattern of expression which is based on differences between the two allotypes. Ly6.1 strains (e.g., A, BALB/c, CBA, C3H/He, DBA/1, NZB) have few Sca1+ resting peripheral lymphocytes, whereas Ly6.2 strains (e.g., AKR, C57BL, C57BR, C57L, DBA/2, PL, SJL, SWR, 129) have relatively high numbers of Sca1+ lymphocytes. The expression of Sca1 is dramatically upregulated in all strains upon cellular activation.
仅用于科研。不用于诊断过程。未经明确授权不得转售。
生物信息学
蛋白别名: locus A/E; Locus AE; Ly-6E; Ly6A; lymphocyte antigen 6 complex, locus E; Lymphocyte antigen 6E; retinoic acid induced gene E; Retinoic acid-induced gene E protein; RIG-E; SCA-2; Stem cell antigen 2; Thymic shared antigen 1; TSA-1; unnamed protein product
基因别名: 9804; Ly67; LY6E; RIG-E; RIGE; SCA-2; SCA2; TSA-1; TSA1
UniProt ID: (Human) Q16553, (Mouse) Q64253
Entrez Gene ID: (Human) 4061, (Mouse) 17069